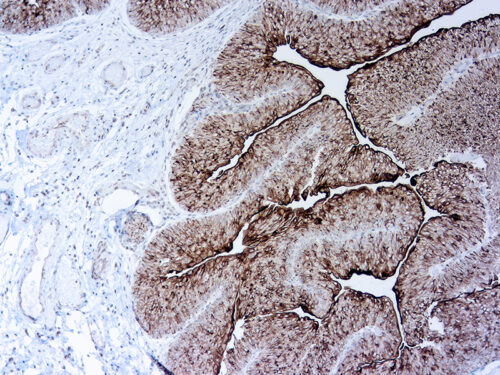

Diagnostic BioSystems is very excited to announce the release of three new primary antibodies specially effective in Bladder Cancer Applications:
Uroplakin II Antibody
Uroplakin II (UPII) is a newly described sensitive marker for urothelial carcinoma (UC).
- Uroplakin II (UPII) and p40 antibodies are high specificity in urothelial carcionoma.
- Uroplakin II is a more sensitive immunohistochemical marker that uroplakin III in urothelial carcinoma.
- Its advantages in the differential diagnosis of urothelial carcinoma and in the detection of tumors of unknown origin.
Ordering information:
| RP177-01 | Uroplakin II (UPK2), Rabbit, Polyclonal, concentrate | 0,1 ml | € 181 ,- |
| RP177-05 | Uroplakin II (UPK2), Rabbit, Polyclonal, concentrate | 0,5 ml | € 442 ,- |
| RP177 | Uroplakin II (UPK2), Rabbit, Polyclonal, concentrate | 1 ml | € 737 ,- |
| PDR177 | Uroplakin II (UPK2), Rabbit, Polyclonal, ready to use | 6 ml | € 408 ,- |
Uroplakin III Antibody
Uroplakin III is specific for tumors of urothelial origin and, when used in combination with other markers, can aid in the diagnosis of primary and metastatic tumors.
- Characterize urothelial lesions and differentiate from prostatic penile, vulvar or renal lesions.
- Applicable for forensic urine identification by immunohistochemisty.
- IHC positive stain in Ovarian Brenner tumor.
Ordering information:
| Mob594-01 | Uroplakin III (AU1), Mouse, Monoclonal, Concentrate | 0,1 ml | € 169 ,- |
| Mob594-05 | Uroplakin III (AU1), Mouse, Monoclonal, Concentrate | 0,5 ml | € 339 ,- |
| Mob594 | Uroplakin III (AU1), Mouse, Monoclonal, Concentrate | 1 ml | € 566 ,- |
| PDM594 | Uroplakin III (AU1), Mouse, Monoclonal, Ready-to-use | 6 ml | € 328 ,- |
Uroplakin II & III Cocktail Antibody
Uroplakin II/III cocktail is specific for tumors of urothelial origin and, when used in combination with other markers, can aid in the diagnosis of primary and metastatic tumors.
- UPII and UPIII are sensitive and highly specific markers for unothelial carcinoma.
- UPII and UPIII have been found to be highly sepcific when evaluated in various normal and neoplastic tissues, including brest, lung, colon, prostate, kidney, ovarian, liver andpancreatic cancers.
- A sensitive marker for urothelial carcinoma and valuable in the discrimination of bladder cancer from renal and prostate carcinomas.
Ordering information:
| RPM001-01 | Uroplakin II & III Cocktail, AU1, Rabbit, Polyclonal, concentrate | 0,1 ml | € 193 ,- |
| RPM001-05 | Uroplakin II & III Cocktail, AU1, Rabbit, Polyclonal, concentrate | 0,5 ml | € 479 ,- |
| RPM001 | Uroplakin II & III Cocktail, AU1, Rabbit, Polyclonal, concentrate | 1 ml | € 805 ,- |
| PDRM002 | Uroplakin II & III Cocktail, AU1, Rabbit, Polyclonal, ready to use | 6 ml | € 453 ,- |